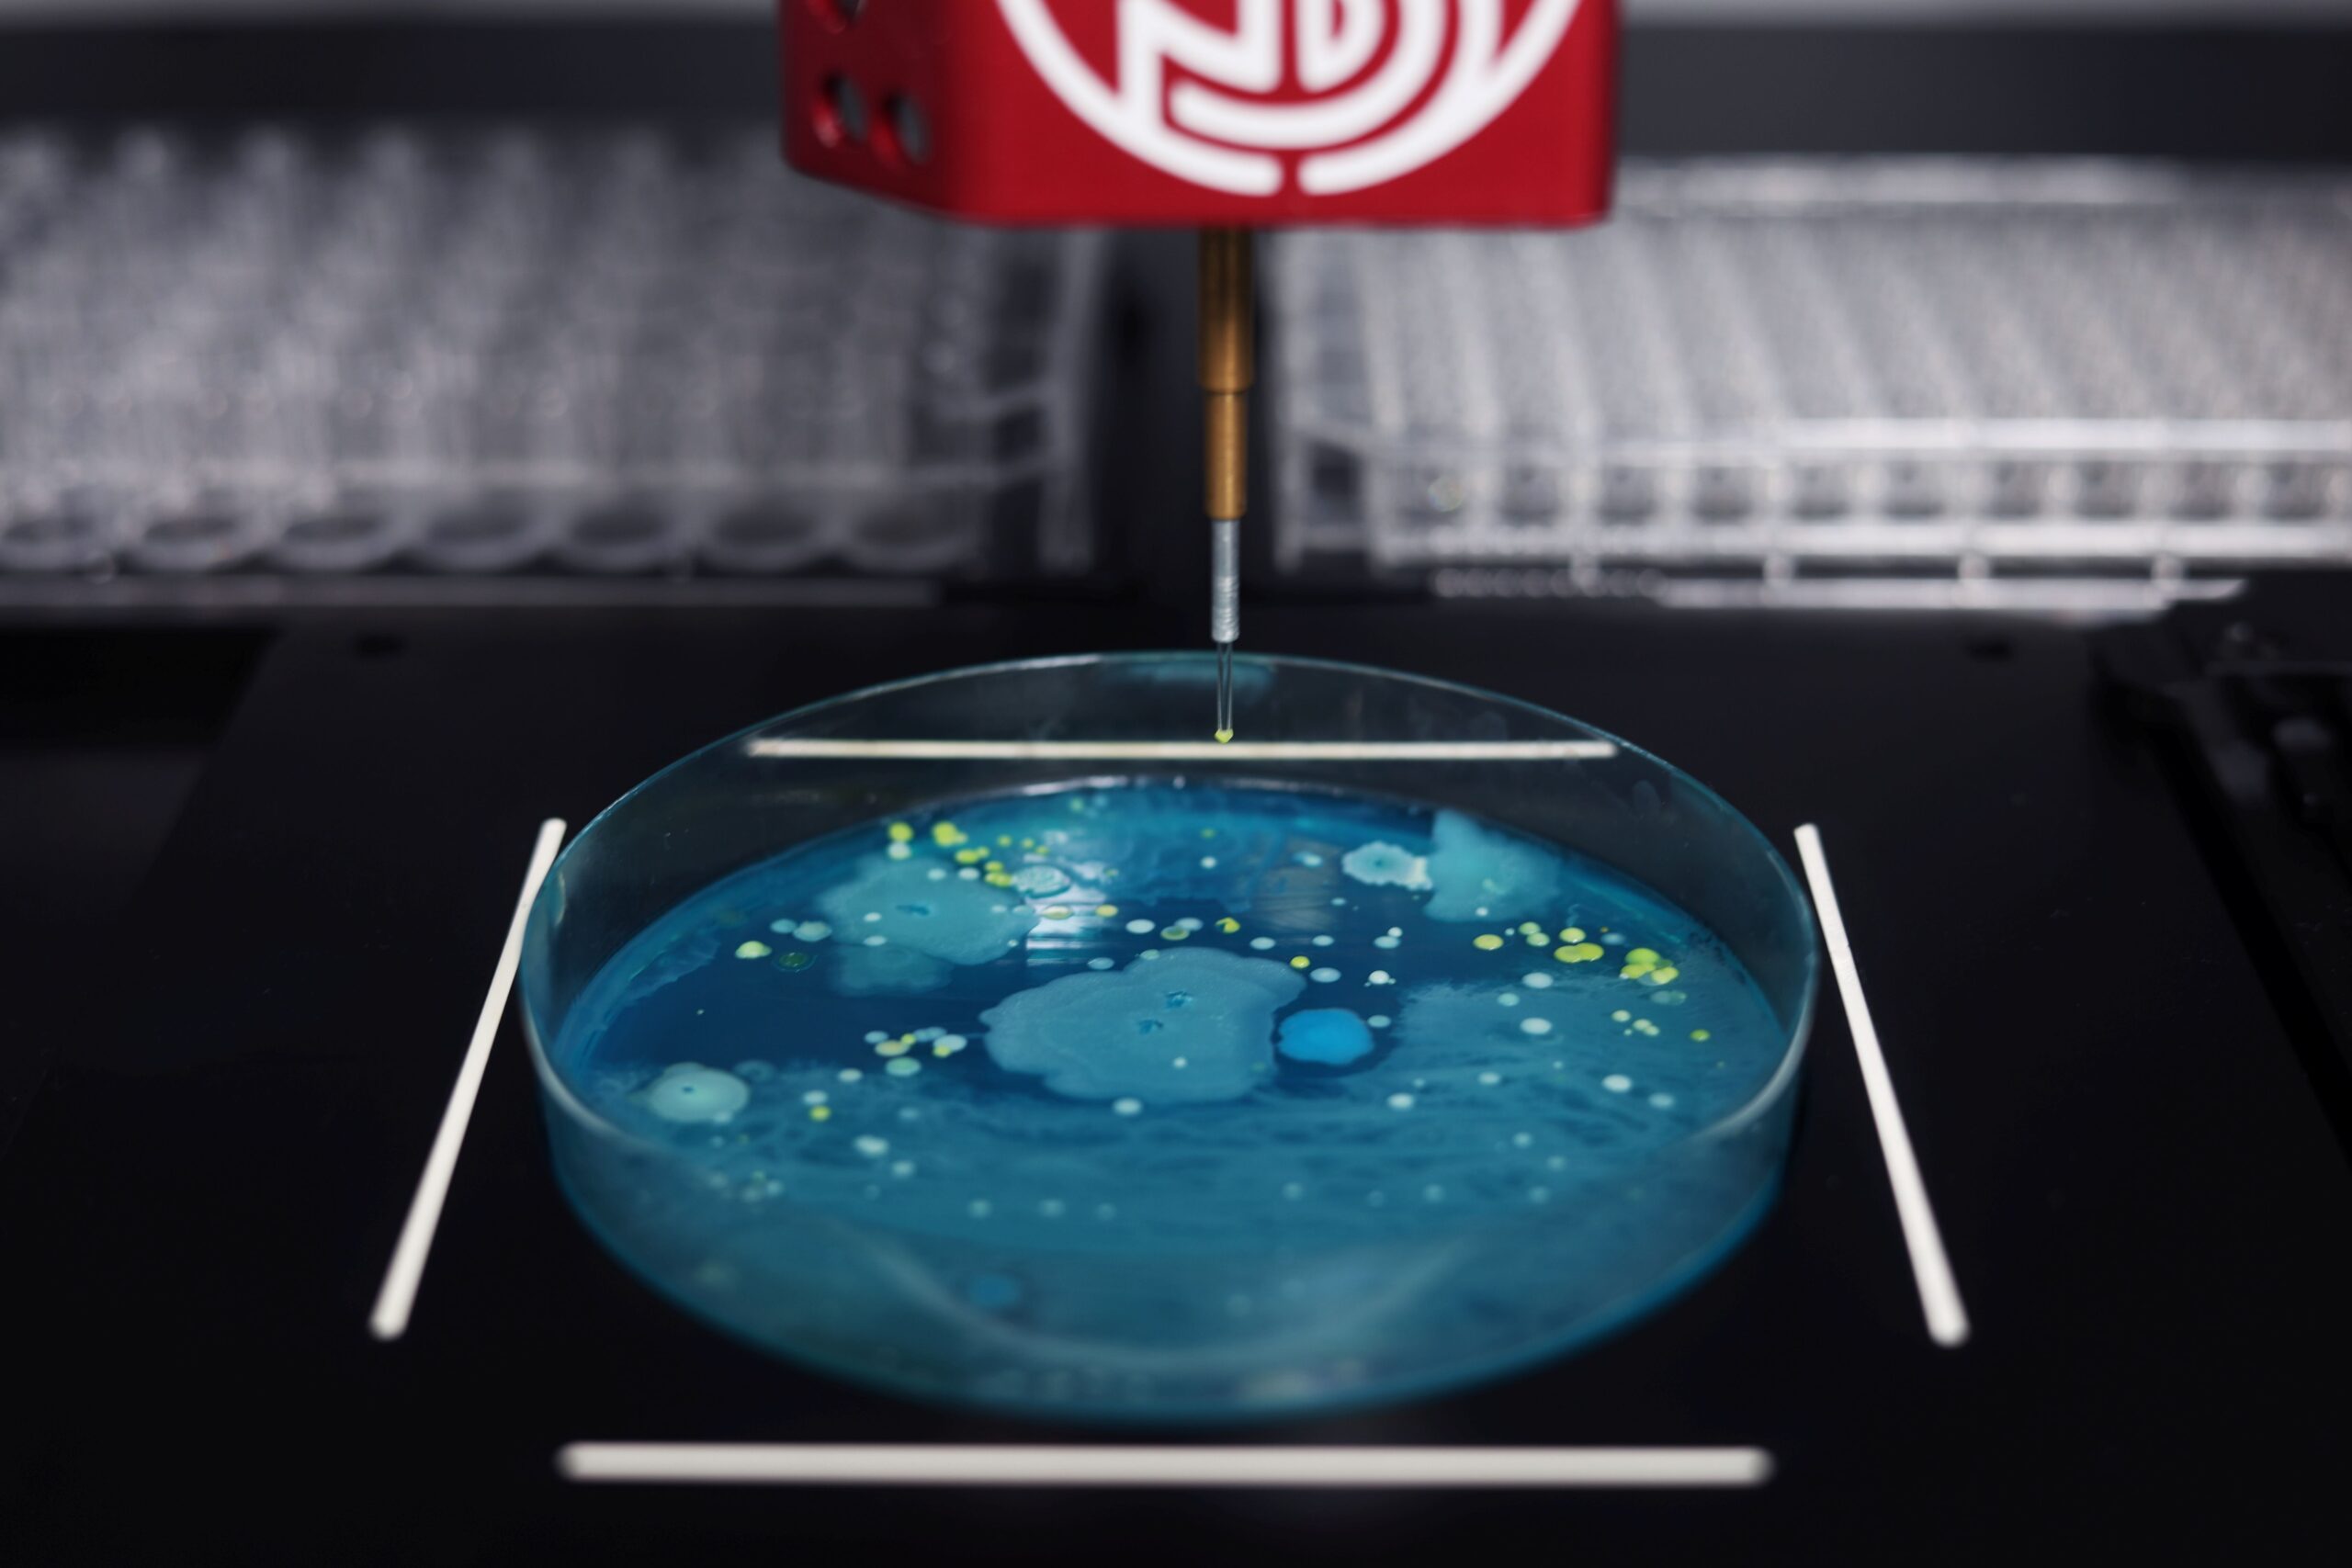
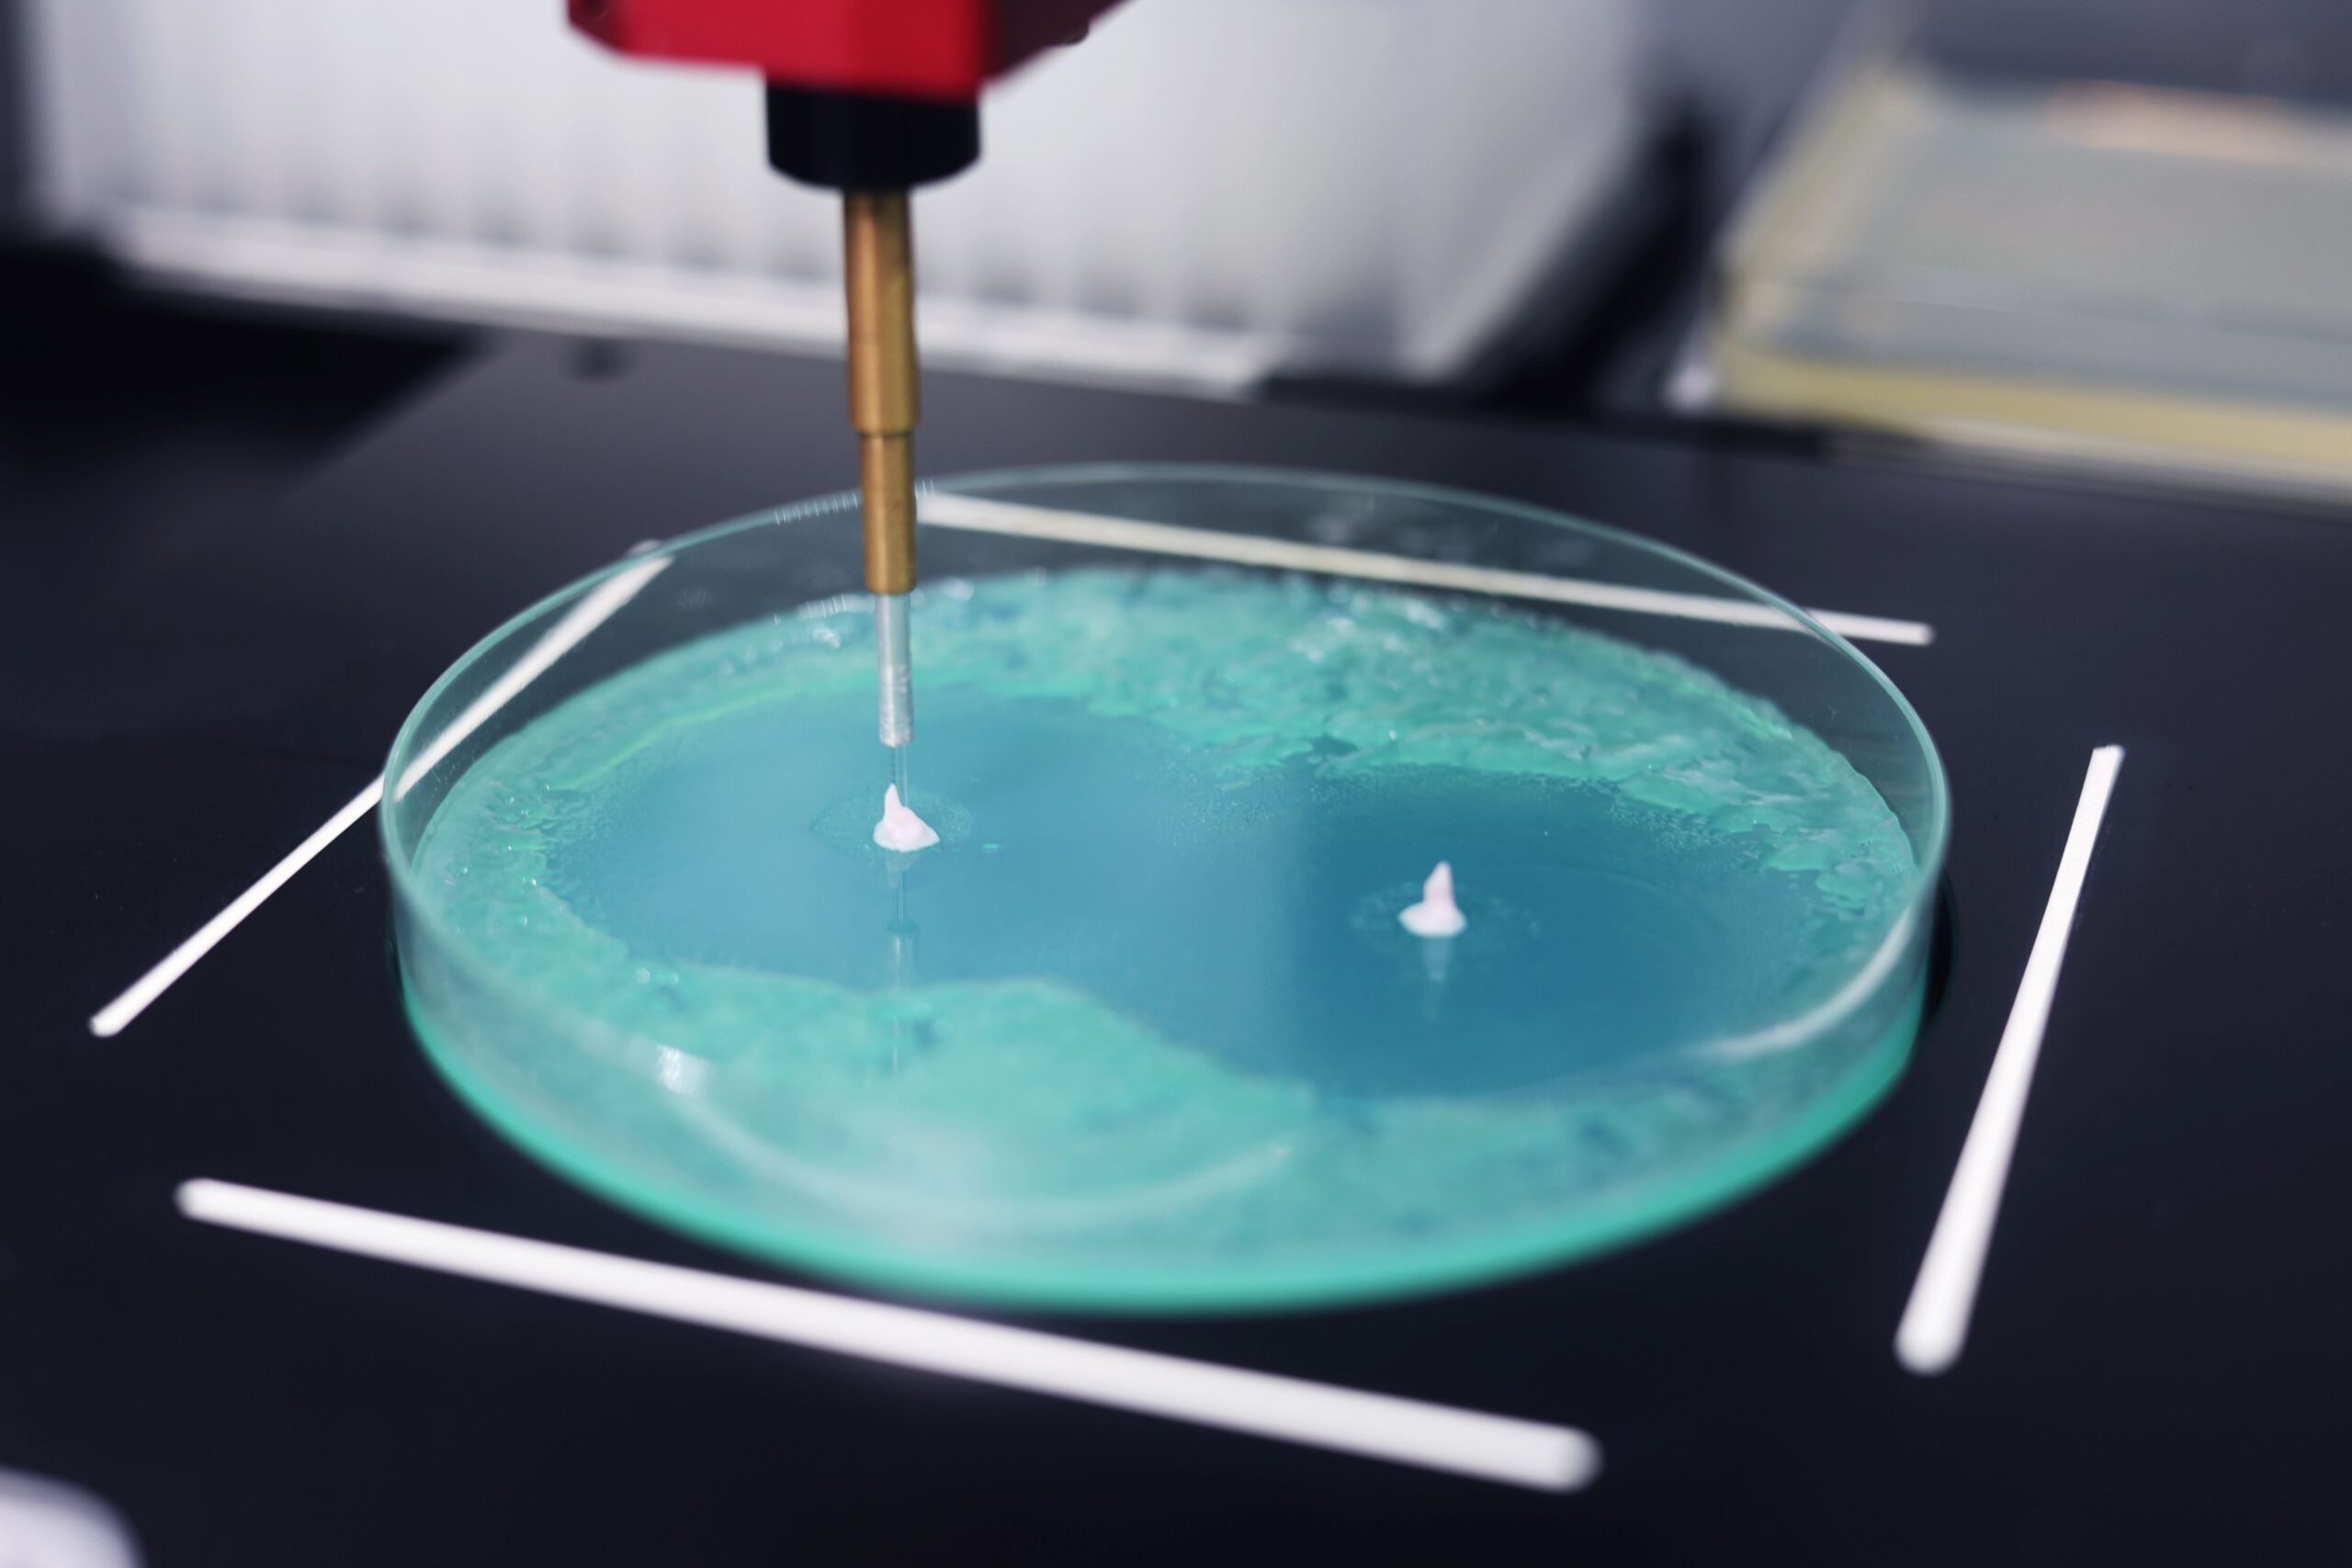

Our world-class colony picker – supercharged! Loaded with features to streamline your colony isolation workflows.

More than just an upgrade
The world’s best colony picker just got better. Loaded with smart tech for the future-facing lab. 6-channel fluorescence and MALDI-TOF plate loading, supported with high spec imaging and processing power.

Advanced detection
Resolve even the smallest colonies with publication-grade image capture and improved colony detection.
2000+ happy microbiologists and 10k citations (and counting!)
Fully loaded with features
Filter your colony selections with 12 different parameters, including size, fluorescence, proximity, circularity and more. Load straight to MALDI-TOF plates (Bruker & Shimadzu) for rapid microbial ID workflows and analyse zones of inhibition.
PIXL+ is as flexible as you need it to be.
Tiny details in focus
Advanced optics capture even the smallest of colonies, with colony detection algorithms trusted on even the most diverse samples. Detect down to 0.25mm and visualise your colonies in high definition.
Door Options
Manual

Maintain safety and minimise contamination.
Space Saving

A space-saving solution for anaerobic chambers, with a built-in laser based safety mechanism.
Fully Automatic

A fully automatic sliding door. If you’re planning to use a robot arm to increase your colony picking walkaway time then this is the choice for you!
Create a colony picking workflow in minutes

1. Login
PIXL+ remembers the last used settings; stores templates and logs user actions and parameters.

2. Select the plate
Petri or rectangular plate. Pick from the whole plate or define sectors of interest.

3. Choose colonies
Filter selected colonies by size, colour, proximity, intensity, shape and fluorescence.

4. Select the target plate
Select the number of replicates; on any density, in any pattern, agar, liquid or MALDI-TOF.

5. Pick colonies
Review your workflow, estimated time, and number of plates required, then press go and walk away.

6. Export data
Export your protocol, colony information, and parameters as a CSV file.
Ready to get started?
Book a 30-minute slot to discuss your workflow with one of our product experts, or ask us anything.
Not seeing the form? Click here to submit an enquiry.